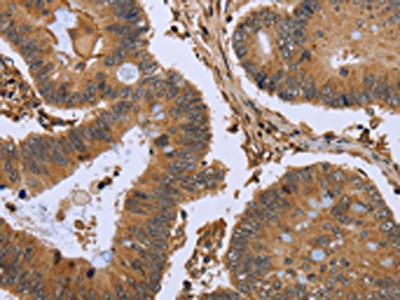

FHL2 Antibody
-
中文名稱:FHL2兔多克隆抗體
-
貨號:CSB-PA798885
-
規格:¥1100
-
圖片:
-
The image on the left is immunohistochemistry of paraffin-embedded Human cervical cancer tissue using CSB-PA798885(FHL2 Antibody) at dilution 1/50, on the right is treated with fusion protein. (Original magnification: ×200)
-
The image on the left is immunohistochemistry of paraffin-embedded Human colon cancer tissue using CSB-PA798885(FHL2 Antibody) at dilution 1/50, on the right is treated with fusion protein. (Original magnification: ×200)
-
Gel: 8%SDS-PAGE, Lysate: 40 μg, Lane: Mouse heart tissue, Primary antibody: CSB-PA798885(FHL2 Antibody) at dilution 1/2400, Secondary antibody: Goat anti rabbit IgG at 1/8000 dilution, Exposure time: 3 seconds
-
-
其他:
產品詳情
-
Uniprot No.:
-
基因名:
-
別名:AAG 11 antibody; AAG11 antibody; Aging associated gene 11 antibody; Down regulated in rhabdomyosarcoma LIM protein antibody; Downregulated in rhabdomyosarcoma LIM protein antibody; DRAL antibody; FHL 2 antibody; FHL-2 antibody; Fhl2 antibody; FHL2 protein antibody; FHL2_HUMAN antibody; Four and a half LIM domain protein 2 antibody; Four and a half LIM domains 2 antibody; Four and a half LIM domains protein 2 antibody; KIAA0990 antibody; LIM domain protein DRAL antibody; Skeletal muscle LIM protein 3 antibody; Skeletal muscle LIM-protein 3 antibody; SLIM 3 antibody; SLIM-3 antibody; SLIM3 antibody
-
宿主:Rabbit
-
反應種屬:Human,Mouse,Rat
-
免疫原:Fusion protein of Human FHL2
-
免疫原種屬:Homo sapiens (Human)
-
標記方式:Non-conjugated
-
抗體亞型:IgG
-
純化方式:Antigen affinity purification
-
濃度:It differs from different batches. Please contact us to confirm it.
-
保存緩沖液:-20°C, pH7.4 PBS, 0.05% NaN3, 40% Glycerol
-
產品提供形式:Liquid
-
應用范圍:ELISA,WB,IHC
-
推薦稀釋比:
Application Recommended Dilution ELISA 1:2000-1:10000 WB 1:1000-1:5000 IHC 1:100-1:300 -
Protocols:
-
儲存條件:Upon receipt, store at -20°C or -80°C. Avoid repeated freeze.
-
貨期:Basically, we can dispatch the products out in 1-3 working days after receiving your orders. Delivery time maybe differs from different purchasing way or location, please kindly consult your local distributors for specific delivery time.
-
用途:For Research Use Only. Not for use in diagnostic or therapeutic procedures.
相關產品
靶點詳情
-
功能:May function as a molecular transmitter linking various signaling pathways to transcriptional regulation. Negatively regulates the transcriptional repressor E4F1 and may function in cell growth. Inhibits the transcriptional activity of FOXO1 and its apoptotic function by enhancing the interaction of FOXO1 with SIRT1 and FOXO1 deacetylation. Negatively regulates the calcineurin/NFAT signaling pathway in cardiomyocytes.
-
基因功能參考文獻:
- FHL2 is an important prognostic factor in cervical cancer (CC) and that it plays a crucial oncoprotein role by promoting cell proliferation and inhibiting apoptosis in CC. PMID: 29800735
- FHL2 and iASPP interacted with each other and co-localized in both nucleus and cytoplasm. Either FHL2 or iASPP silenced could reduce cell proliferation, induce cell cycle arrest at G0/G1 phase, and increase cell apoptosis. PMID: 28402264
- FHL2 phosphorylation by FAK is a critical, mechanically dependent step in signaling from soft matrices to the nucleus to inhibit cell proliferation by increasing p21 expression. PMID: 27742790
- FHL2 facilitates ovarian granulosa cell tumor progression via controlling AKT1 transcription. PMID: 27415427
- we determined the molecular mechanism responsible for IER3 degradation, involving a ternary complex of IER3, MDM2 and FHL2, which may contribute to cervical tumor growth. Furthermore, we demonstrated that FHL2 serves as a scaffold for E3 ligase and its substrate during the ubiquitination reaction, a function that has not been previously reported for this protein PMID: 26973248
- FHL2 interacts with ADAM-17 in normal, dysplastic and malignant colon epithelial cells. Colocalisation of these proteins is more frequent in malignant than in normal and dysplastic cells, suggesting a role for ADAM-17/FHL2 complex in the development of colorectal cancer. PMID: 28349819
- FHL2 overexpression could enhance the differentiation and mineralization of human dental pulp cells PMID: 25662359
- findings show that mAbp1 and FHL2 are novel binding partners that differentially regulate Rho GTPase signaling and MTLn3 breast cancer cell invasion PMID: 27129278
- These results identify FHL2 as a novel gene associated with asthma severity in human. PMID: 26222912
- FHL2 might interact with Runx2 to mediate mesenchymal cell differentiation at the early stages of tooth development and human dental pulp cell differentiation. PMID: 26759258
- FHL2 overexpression could contribute to the growth, proliferation, invasiveness, and metastasis of human tongue squamous cell carcinoma. PMID: 26759260
- KLF8-induced FHL2 activation is a novel and critical signaling mechanism underlying human colorectal cancer invasion and metastasis. PMID: 26320172
- Studies indicate that the LIM-only protein FHL2 interactome is functionally involved in the cardiovascular system. PMID: 26548523
- we conclude that FHL2 has both structural and functional protein-protein interactions with b-catenin in the podocyte nucleus and that FHL2 protein inhibition can mitigate Wnt/b-catenin-induced podocytopathy. PMID: 25855776
- Describe the molecular network governing FHL2 expression, and FHL2-linked cancers and the underlying molecular machinery. Review. PMID: 26211626
- Tumoral expression of nuclear cofactor FHL2 is associated with lymphatic metastasis in sporadic but not in hereditary nonpolyposis colorectal cancer-associated colorectal cancer. PMID: 25554651
- results provide evidence for the importance of the focal adhesion protein FHL2 in pancreatic cancer cell survival, proliferation and radiosensitivity PMID: 25917075
- FHL2 is down-regulated in HCM; both FHL2 wild type and variants partially protected phenylephrine- or endothelin-1-induced hypertrophy in cardiac myocytes PMID: 25358972
- FHL2 downregulation has a role in the pathogenesis of myeloid malignancies. PMID: 25179730
- HPV16 E6 oncoprotein interacted and impaired the subcellular distribution of FHL2. PMID: 25540819
- tumoural TGF-beta1 secretion seems to induce nuclear translocation of co-factor FHL2 mediating progressive keratin expression in pilomatricoma. PMID: 25477051
- Enhanced FHL2 and TGF-beta1 expression is correlated with poor survival in human malignant melanoma PMID: 25596251
- FHL2 is a transcriptional coactivator of LXRs and may be an important determinant of cholesterol metabolism in SMCs PMID: 25332231
- High FHL2 expression is associated with colon cancer. PMID: 24008552
- Data suggest Fhl1 (four-and-a-half LIM domains protein 1) and FHL2 (four-and-a-half LIM domains protein 2) bind to and regulate activity of Prkd1 (protein kinase D 1) in cardiac/ventricular myocytes; knockdown of FHL2 down-regulates Prkd1 activation. PMID: 24219103
- The calpain-cleaved filamin fragment and FHL2 are present in the nucleus only in CRPC. PMID: 23801747
- higher FHL2 expression in malignant epithelial cells correlates with progressive disease in patients with colorectal cancer, suggesting that FHL2 is a prognostic indicator for the development of metachronous metastases and for overall survival PMID: 23756870
- FHL2 acts as an oncogene in osteosarcoma cells and contributes to tumorigenesis through Wnt signaling PMID: 23383046
- PCBP2 is an RNA-binding protein that modulates glioma growth by regulating FHL3 PMID: 23585479
- The four and a half LIM-only protein 2 regulates liver homeostasis and contributes to carcinogenesis. PMID: 22796152
- Deletion of FHL2 protein by FHL2 small interfering RNA impaired VEGF production under hypoxia conditions, and also suppressed endothelial progenitor cell angiogenic functions. PMID: 23413425
- FHL2 increases the stability of the TGF-beta pathway positive regulator Arkadia by inhibiting its ubiquitination and cooperates with Arkadia to activate TGF-beta signaling. PMID: 23212909
- Overexpression of Id3 markedly promoted the proliferation and invasive capacity of MCF-7 cells; however, these effects were significantly suppressed by the overexpression of FHL2. PMID: 22882857
- FHL2 modulates calcineurin-dependent activation of NFAT target genes. PMID: 22851699
- On influenza A virus infection FHL2 translocates into the nucleus, potentiating the IRF-3-dependent transcription of the IFNbeta gene. PMID: 22417706
- FHL2 directly interacts with HIF-1alpha to repress transcriptional activity. PMID: 22219185
- association of FHL2 with Nur77 plays a pivotal role in vascular disease. PMID: 22049082
- Overexpression of FHL2 in peritumoural myofibroblasts correlated to lymphatic metastasis in sporadic colon cancer but not in hereditary non-polyposis colorectal cancer. PMID: 21826055
- Our data suggest a role of FHL2 in odontoblast differentiation and dentin formation both in normal and in carious teeth PMID: 21308406
- In human colorectal carcinoma but not in low-grade dysplasia, we detected up-regulation and enhanced nuclear localization of FHL2, indicating the activation of FHL2 during the development of malignancy PMID: 20442768
- our results indicate FHL2 could exert anti-apoptotic effect independent of tumor growth suppression PMID: 21377781
- cooperative regulation of estrogen signaling by FHL2 and Smad4 in breast cancer cells, and might provide a new regulation mechanism underlying breast cancer development and progression PMID: 20734429
- In the absence of transgenic FHL2, CCL19-induced bone marrow-derived dendritic cell migratory speed, persistence, and directionality were markedly increased in vitro and in vivo. PMID: 20592280
- Sp1 up-regulates FHL2 expression in gastrointestinal cancers through transcription regulation. PMID: 20607723
- FHL2 is a potent epithelial-mesenchymal transition (EMT) inducer and might be an important mediator for invasion and/or metastasis of colon cancer. PMID: 20460358
- Aryl hydrocarbon receptor (AhR) modulation of androgen receptor activity is differentially altered by the level of FHL2 and AhR present in the cell. PMID: 19815066
- Insulin-like growth factor-binding protein 5 (IGFBP-5) interacts with a four and a half LIM protein 2 (FHL2). PMID: 11821401
- TUCAN/CARDINAL and DRAL participate in a common pathway for modulation of NF-kappaB activation. PMID: 12067710
- evidence of a functional interaction between the promyelocytic leukemia zinc finger protein (PLZF) and DRAL/FHL2 PMID: 12145280
- FHL2 might enforce beta-catenin transactivation activity in cancer cells PMID: 12466281
顯示更多
收起更多
-
亞細胞定位:Cytoplasm. Nucleus. Cytoplasm, myofibril, sarcomere, Z line.
-
組織特異性:Expressed in skeletal muscle and heart.
-
數據庫鏈接:
Most popular with customers
-
-
YWHAB Recombinant Monoclonal Antibody
Applications: ELISA, WB, IHC, IF, FC
Species Reactivity: Human, Mouse, Rat
-
Phospho-YAP1 (S127) Recombinant Monoclonal Antibody
Applications: ELISA, WB, IHC
Species Reactivity: Human
-
-
-
-
-